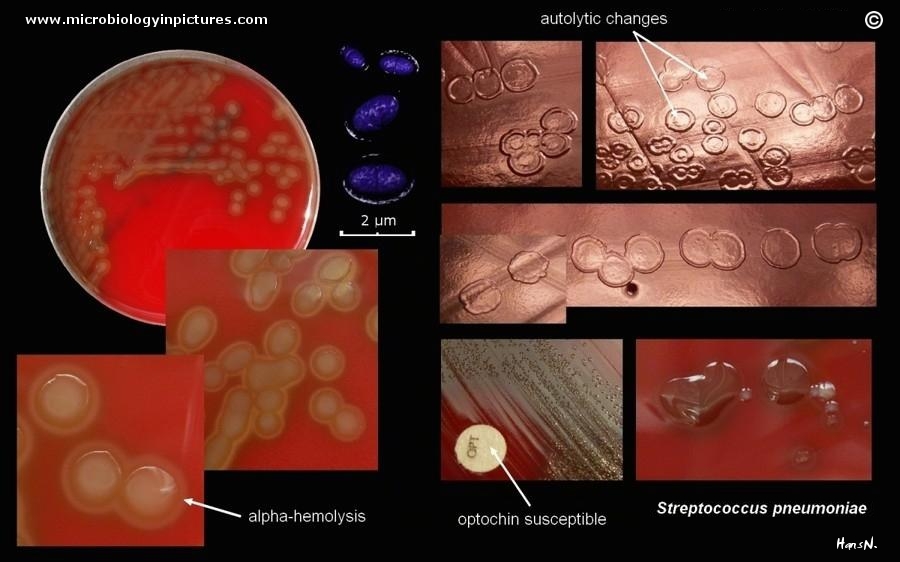

Overview of the Streptococcus genus, and how are species classified?
Many species (>30) of gram positive streptococci. There are five significant human pathogens of streptococci.
Most are facultative anaerobic.
Require blood agar or chocolate agar cultivation, will not grow on simple agar
Catalase neg
Are beta-alpha, or gamma (non) hemolyzing.
Classified by :
1) Hemolysis: alpha beta or gamma
2) Lancefield group: based on the “C” aminopolysaccharide in the cell wall.
3) Serotype: based on the “M” protein in the cell wall.
4) 16sRNA coding DNA sequence: there are 6 clusters, which have similar pathologies or ecologies.
What are the Lancefield groups?
How is a bacteria’s Lancefield group determined?
What are the bacteria of groups A, B, and D?
What are the two significant human streptococci that do not have Lancefield groups?
The group of bacteria that express a specific antigen epitope, can be identified by a specific antibody, lancefield groups go from A thru S.
The epitope is a specific amino-sugar moiety that is expressed by that bacterial group
The Lancefield group is determined by latex agglutination test with the lancefield antibodies.
Streptococcus pyogenes = A
Streptococcus agalactiae = B
Enterococcus faecalis and Streptococcus bovis = D
- S. pneumoniae* has no lancefield antigens
- Viridans streptococci* have no lancefield antigens.
Streptococcus genus morphology, cultivation
Gram positive cocci in chains
are “demanding” require blood agar media
Remember that the Pie Genies demand blood! (and so do all their other streptococcus friends)
form small ~1 mm round colonies “needletip colonies”
Catalase neg
General description, morphology, culture of Streptococcus pyogenes
Gram positive streptococcus (long chains of spheres) ~1uM diameter
demanding, requires blood agar.
Hyaluronic acid capsule
Wide beta hemolysis, ~1 centimeter, around the colonies
small colorless needletip colonies.
A - Lancefield group
Is PYR positive Pyrrolidonyl Arylamidase, can hydrolyze this substrate.
Expresses streptolysins S and O (hemolysins)
Streptococcus pyogenes virulence factors
Hyaluronic acid capsule
Lipoteichoic acid,
F-protein - Fibronectin binding protein, mediates cell attachment.
M-protein - inhibits C3 convertase, prevents opsonization
Streptolysins O and S (hemolysins, O-oxygen labile S-stabile in oxygen)
NADase
Hyaluronidase
Streptokinase - Converts Plasminogen to Plasmin, which then lyses fibrin clots.
Streptodornase (DNAse)
“C” carbohydrates R and T
Erythorogenic toxins - capillary toxin, scarlet fever toxin. SpeA, SpeB, SpeC.
SpeA and SpeC are Superantigens, and SpeB is a protease causing necrotising fasciitis.
How is streptococcus diagnosed
by determining the ASO titer (concentration of anti-Streptolysin O antibodies in the blood) of the blood. If it is abnormally high, then there is an active streptococcus infection or may indicate a post-streptococcal syndrome.
How is an ASO titer performed?
Antibody titers against streptolysin O in patients serum are a useful indicator of a recent S. pyogenes infection.
- serial dilutions of patient’s serum are prepared
- Streptolysin ‘O’ (antigen) added the tubes
- Incubation – for 15 minutes at 37 C
If antibody is present it neutralizes the streptolysin which is then no longer to free to lyse
RBCs
We can read the end titer corresponds to a serum dilution (for example 1/160-200 = 60-200
Todd units of antistreptolysin / ml is considered abnormally high)
What clinical disorders are caused by S. pyogenes
Streptococcus pyogenes causes
1) Purulent infections
Impetigo contagiosa - yellow/orange crusty skin infection, contagious on contact
Phlegmone - deep tissue infection of the subdermal adipose or fascia. often seen in the extremities
Erysipelas - red swollen superficial skin infection with well demarcated borders.
Puerperal fever - child bedfever, transmitted to mothers giving birth by doctors hands, demonstrated by Ignaz Semmelweis.
Follicular tonsillitis, pharnygitis, sinusitis - classic “Strep throat” with follicular exudate on the tonsils.
Meningitis
Pneumonia
Endocarditis
Necrotising Fasciitis - infection of the fascia layer which rapidly spreads, causing swelling and then subsequent death of the overlying tissue all the way down to the fascia. Must be treated by amputation of that muscle/fascia.
2) Toxin mediated infections
Scarlet fever - mediated by erythrogen toxin. Which destroys capillary endothelial cells causing RBC leakage and redness.
- Widespread redness results after 2 days, called exanthema.
- On the tongue, this causes papillary hypertrophy, resulting in strawberry tongue.
Toxic shock syndrome -
3) Post-streptococcal diseases
Rheumatic fever: Type 2 hypersensitivity (antibody mediated hypersensitivity RXN). Cardiomyocytes surface antigen is similar to M-protein on S pyogenes, and autoimmune antibodies continue to be produces and attack the heart muscle. Pancarditis (damage of the heart muscle), and endocarditis (damage of the valves) occur.
Acute Glomerulonephritis (GN): Type 3 hypersensitivity (immune complex mediated) Deposition of immune complexes in the glomeruli basal membrane, damage, inflammation glomerulonephritis
Polyarthritis: Also Type 3 reaction, Immune complexes in the joints.
Erythema nodosum: Type 3. Subcutaneous, adipose deposition of immunce complexes
What causes scarlet fever?
How many times can Scarlet fever be acquired?
How many times can tonsillitis follicularis be acquired?
Caused by erythrogenic toxin that is released after infection of S pyogenes by a bacteriophage stimulates the bacteria to produce the toxin.
During scarlet fever antibodies agaisnt the toxin are produced, so scarlet fever can only occur once
Scarlet fever is caused by many different serotypes/strains of streptococcus pyogenes, so the follicular tonsillitis or phayrngitis caused by them can occur many times.
What is the treatment for Streptococcus pyogenes?
Prevention?
Penicillins
Streptococci are almost always very susceptible to penicillin.
but as usual, antibiogram should be performed to confirm this.
If patient is allergic to penicillin, Macrolides (Erythromicin, 50S inhibits RNA translocation through ribosome)
For skin lesions or fasciitis, Local antiseptics and/or surgical removal
Prevention:
No specific prevention exists,
Post-streptococcal diseases are prevented by long-0term penicillin treatment.
Streptococcus a….
name, morphology, culture
Streptococcus agalactiae
Gram positive streptococci, chains of cocci, 1uM
Demanding, blood agar. A galactic baby demands blood.
Narrow beta-hemolysis (as opposed to S. pyogenes which is very wide)
tiny, needletip colonies
CAMP test + (like other group Bs)
Bacitracin resistant
Lancefield group B
Hippurate+, hydrolyzes Na-hippurate.
The #1 cause of meningitis in neonates.
Also common cause of Sepsis and Pneumonia in neonates.
Usually infected when the baby passes through the birth canal, and all pregnant women should be check at 35 weeks.

Streptococcus a…
Pathogenicity
Clinical diseases
Treatment
Prevention
Streptococcus agalactiae
Pathogenic colonization of the vagina
Can cause abortion during pregnancy
Can infect babies during birth: newborn pneumonia, ARDS, meningitis, or sepsis
Is the most common cause of meningitis in infants, and a leading cause of pneumonia and sepsis.
The mother is usually asymptomatic, therefore ALL pregnant women need to be screened during the third trimester, 35th week.
Penicillin/Ampicillin used for both treatment and prophylactic prevention.
Enterococcus genus
morphology, culture
Gram positive
Slightly elongated cocci, in short chains and in pairs
Lancefield Group D
Enterococcus do NOT demand blood, like the other streptococcus.
On simple Agar - small greyish, shiny colonies
On blood agar - small greyish, shiny, usually alpha hemolytic, but different strains may be beta- or non-hemolytic
What are the group D streptococci?
Enterococci and non enterococcal group D streptococci!
Diagnosing Enterococcus faecalis
Selective culturing on Bile Esculin Agar, aka E67 agar, produces black colonies
Catalase neg
PYR positive, can hydrolyze PYR, generates color change
Esculin Positive, can hydrolyze esculin, generates color change.
Grows in 6.5% agar
mild cold tolerance, grows at 45 C
What is the habitat/reservoir of Streptococcus faecalis?
How is it transmitted?
What are the clinical diseases?
Prevention?
It is normal flora of the GI (entero)
It is transmitted as a nosocomial infections often in the found in hospital ICU’s
Usually from the patients own GI population getting into an area it shouldn’t.
From urinary or GI tract wounds.
Can cause:
After GI perforation: sepsis, peritonitis.
After a surgery can cause infection of any area the wound opens into -> meningitis, endocarditis, bactermia,.. etc.
Virulence factors of Enterococcus faecalis?
There are no well defined virulence factors, as they are normally commensal organisms of the GI and considered beneficial normally.
Streptococcus faecalis
Treatment
Prevention
Treatment: Antibiogram
Enterococcus very often has many resistances
Intrinsic resistance to cephalosporins, monobactams
Intrinsic mild resistance to aminoglycosides
Acquired resistance to fluoroquinolones and vancomycin.
usual treatment in serious infections is Vancomycin and Aminoglycosides.
In addition to all of the antibiotics, E faecalis is the most resistant non-spore forming bacteria,
highly heat, dessicant, and salt resistant
Prevention:
No specific prevention available other than attempting to use good aseptic/sterile technique during surgery and recovery periods.
What is the Streptococcus viridans group of bacteria?
S. Mutans, Mitis, Milleri, Salivarius, Sanguis. Anginosus
A heterogenous collection of Alpha-hemolytic streptococci of short chains or pairs. alpha hemolytic –> viridans
They are Anaerobic and some are microaerophilic. (two A’s Alpha-hemolytic and Anaerobic streptococci)
They are normaflora of the oral cavity and GI tract. Are responsible for abscess in the gums, and dental caries with poor oral hygeine
Streptococcus viridans in the blood stream can cause subacute endocarditis. So people with dental caries and gingivitis are at risk for endocarditis.
How is Streptococcus viridans differentiated from Streptococcus pneumoniae?
By demonstrating Optochin Resistance
Pneumococcus (Streptococcus pneumoniae) is sensitive to optorchin and Viridans is resistant.
Or by bile solubility
Pneumococcus will be lysed and killed by 2% bile salt in the agar, while S viridans are bile resistant
Or by Inulin fermentation
Pneumococcus can ferment inulin
What clinical diseases are caused by Streptococcus viridans?
What is the treatment?
Dental caries, Gingivial abscess
Endocarditis
Sepsis
Treatment: long term (6 weeks) beta-lactam plus aminoglycoside
Penicillin or vancomycin plus gentamicin.
Which specific bacteria are responsible for dental caries?
Streptococcus mutans of the viridans group
in conjunction with Lactobacillus bacteria species
S mutans and Lactobacilli are members of the oral normaflora. but in poor hygeine grow too much.
- S mutans* secretes extracellular polysaccharides that coat the teeth and provide growth environment for more bacteria, it also produces lactic and other acids from sugars in the oral cavity
- Lactobacillus* also produces more lactic acid and contributes.
Both are able to live fine in low pH values, and thus keep living even inside of the low pH lesion that is eroding the teeth.
Streptococcus pneumoniae
Morphology
Culture, diagnosis
aka Pneumococcus
Gram positive “lance- or flame-shaped” diplococci, pairs of oval shaped bacteria
Demanding, cultured on blood or chocolate agar.
Gray, shiny colonies with alpha-hemolysis (green)
Colonies undergo autolysis as they age, forming ring shaped “umbilibus”
Some strains have capsules and have a large mucinous apearance to the colonies.
Bile salt soluble (lyses if they’re present in the agar)
Optorchin antibiotic sensitive
Quellung reaction positive
Alpha hemolytic
Has no lancefield group class
But, microscopically, it looks like a pair of lance shaped diplococci. (alpha night tournament)
Streptococcus pneumoniae
Habitat and infection methods
~5-10% of the population carry it in the respiratory tract and nasopharynx
Transmitted by contact with respiratory droplets from a person carrying it.


